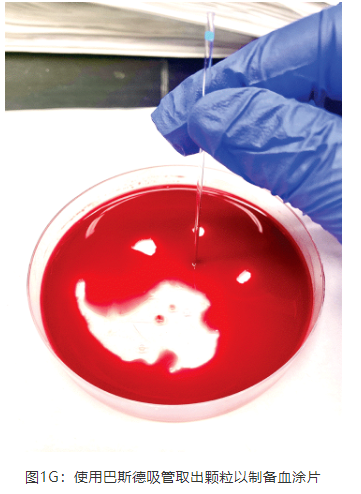

骨髓穿刺抽吸技术
骨髓穿刺抽吸技术的早期发展主要集中在人类医学领域,随后逐渐应用于动物研究。最初的技术较为简单,主要用于获取骨髓样本以进行血液学和病理学分析。随着研究需求的增加,骨髓穿刺抽吸的技术逐渐得到了改进和优化,设备改进方面引入了专用的骨髓穿刺针,这些穿刺针具备更好的设计可以减少组织损伤和提高样本质量,以及在操作过程中引入严格的无菌技术以减少感染的风险。
骨髓穿刺技术不仅在医学研究中得到广泛应用还扩展到多个领域。药物研发,评估新药对骨髓的影响,尤其是抗癌药和免疫抑制药物的研究中;毒理学研究中,同样需要研究有毒物质对骨髓的影响;此外,基因治疗,通过获取骨髓细胞进行基因组研究和基因编辑实验等都需要进行骨髓穿刺。本文将介绍实验犬的骨髓穿刺抽吸技术。
采集部位
对于犬,骨髓样本通常从股骨转子窝、肱骨近端或髂骨翼采集,其他部位包括胸骨、肋骨。如果骨盆和股骨区域含有丰富的脂肪组织,采集则会变得更具挑战性。下文主要讲述犬肱骨近端骨髓采集的操作程序。
肱骨近端骨髓采集
材料和设备
无菌手套
电动剪毛器和清洁溶液
局部麻醉药(如利多卡因、布比卡因)
含有2.5% - 3%乙二胺四乙酸溶液(EDTA约2 mL)的培养皿
玻璃显微镜载玻片
显微血细胞比容毛细血管(图A),有毛细血管球
11号手术刀片
无菌纱布
10或12ml注射器
14G至18G带针芯的骨髓针(图B和C)

操作步骤
1、在进行深度镇静或全身麻醉后,动物侧卧位,修剪采集部位的毛发,可以在采集部位皮下注射局部麻醉剂(如利多卡因、布比卡因),采集部位无菌清洗。如图1A。

2、打开并佩戴无菌手套。助理辅助将穿刺针、注射器和手术刀片打开并放入无菌区域,或将这些物品以无菌的方式递给术者。使用10或12ml的注射器,在保持无菌的情况下,抽取约1ml的EDTA溶液。如图1B 。

3、将注射器放置在无菌区域内。移除穿刺针的盖子和针芯,通过顺时针旋转确保针头的防护装置牢固地连接在针头的基部。将含有EDTA的注射器连接到针头的顶部并旋紧。通过将EDTA喷回培养皿来灌注针头,留下约0.5 mL的EDTA在注射器中。灌注时保持在培养皿上方,不要让无菌针头的尖端接触培养皿,然后将注射器从针头上移除,置于无菌区域内。重新装上针芯和盖子。注:在大型犬中,可以移除针头防护装置,以方便进入髓腔。如图1C。

4、触摸并确定肱骨近端外侧的平坦区域,位于大结节的远端。确定肩胛骨和肱骨之间的肩关节,以确保不会误采到该区域。在平坦区域正上方的皮肤上切开一个小口。如图1D。

5、牵拉皮肤,将针头“弹入”切口,确保针头已穿透深层皮下组织。重新确认肱骨近端外侧的平坦区域,位于大结节的远端。将针尖直接放在骨头上,垂直于平面。以顺时针和逆时针旋转的方式适度施加压力,直至针头穿透近端骨皮质。穿透皮质后,减小角度,使针头朝向肘部,平行于髓腔。继续扭转,直到针完全嵌入骨内。如图1E。

6、移除盖子和针芯,并迅速连接含有EDTA的注射器。抽吸至可见红骨髓(2 ~ 5 mL足够),并将内容物排出到培养皿。如图1F。

7、骨髓包含在白色的针状物中,表明穿刺成功。使用毛细管或带有毛细管球或移液管球的巴斯德移液管取出并排出这些颗粒,用于血涂片制备。每片至少需要1个针状物;然而,建议每张载玻片至少有3 ~ 5个较大的针状物,以进行充分评估。任何剩余的骨髓内容物都可以收集到EDTA管中,并与载玻片一起送往实验室。如图1G。
8、在动物恢复后给与镇痛药物,并根据需要继续使用。
潜在的不良反应、缓解措施或治疗方法
1、采样部位感染,但这种情况很少见
2、对软组织如神经、肌肉和关节表面的创伤
3、采样部位出血
4、术后疼痛
缓解措施
密切注意无菌技术
仔细辨别解剖标志,准备骨骼/骨标本以正确找到解剖标志,避免对周围组织造成意外创伤
对采样部位施加直接压力,髓内出血不会引起大的问题,因为血液会迅速被吸收
术后疼痛通常是短暂的,镇痛药用作镇静/麻醉的预药通常是足够的,但如果需要也可以在术后使用
小结
为了提高骨髓穿刺抽吸的成功率和样本质量,必须制定全面的标准操作程序(SOP),涵盖动物准备、麻醉管理、穿刺操作及样本处理等各个环节,并对实验人员进行系统且广泛的培训。此外,实验研究人员应持续优化和改进技术,精细化操作流程,提升效率与准确性,从而为生物医学研究提供高质量的样本和可靠的数据支持。



